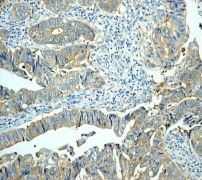

> Antigen, Antibodies, ELISA, Western Blot > Primary Antibody > Monoclonal Antibodies > ST13/HIP AntibodyBrand |
Leading Biology | Catalog Number |
AMM07993G |
Product Type |
Monoclonal Antibodies | Field of Research |
|
Product Overview |
We constantly strive to ensure we provide our customers with the best antibodies. As a result of this work we offer this antibody in purified format.
We are in the process of updating our datasheets. If you have any questions regarding this update, please feel free to contact our technical support team.
This product is a high quality ST13/HIP antibody.
|
||
Molecular Weight |
41332 Da
|
||
Cellular Localization |
Antigen Cellular Localization:
Cytoplasm.
|
||
Host |
Rabbit
|
||
Species Reactivity |
Human, Mouse
|
||
Target |
A synthetic peptide corresponding to residues near the C-terminus of human Hsc70 Interacting Protein/HIP was used as an immunogen.
|
||
Clone |
EP3264
|
||
Symbol |
AAG2, FAM10A1, HIP, SNC6
|
||
GeneID |
|||
UniProt ID |
|||
Function |
One HIP oligomer binds the ATPase domains of at least two HSC70 molecules dependent on activation of the HSC70 ATPase by HSP40. Stabilizes the ADP state of HSC70 that has a high affinity for substrate protein. Through its own chaperone activity, it may contribute to the interaction of HSC70 with various target proteins (By similarity).
|
||
Summary |
ST13/HIP is a cytoplasmic co-chaperone involved in the regulation of Hsc70 chaperone activity and the maturation of progesterone receptor. ST13/HIP is made of two structural and functional domains, an NH2-terminal domain, responsible for the dimerization and the overall asymmetry of the molecule, and a COOH-terminal globular domain, both involved in Hsc70 and unfolded protein binding (1). By collaborating with other positive co-factors such as Hsp40 and the Hsp70-Hsp90 organizing protein (Hop), or competing with negative co-factors such as Bcl2-associated athanogen 1 (Bag1), ST13/HIP facilitates may facilitate the chaperone function of Hsc/Hsp70 in protein folding and repair, and in controlling the activity of regulatory proteins such as steroid receptors and regulators of proliferation or apoptosis (2).
|
||
Form |
50 mM Tris-Glycine (pH 7.4), 0.15 M NaCl, 40% Glycerol, 0.01% sodium azide and 0.05% BSA. |
||
Storage & Stability |
Store at +4°C short term. For long-term storage, aliquot and store at -20°C or below. Stable for 12 months at -20°C. Avoid repeated freeze-thaw cycles.
|
||
Applications |
WB, IHC
|
||
Dilution |
WB~~1:1000~10000
IHC~~1:100~250
|
||
Synonyms |
Hsc70-interacting protein, Hip, Aging-associated protein 2, Progesterone receptor-associated p48 protein, Protein FAM10A1, Putative tumor suppressor ST13, Renal carcinoma antigen NY-REN-33, Suppression of tumorigenicity 13 protein, ST13, AAG2, FAM10A1, HIP, SNC6
|
||
Images |

A. Western blot analysis on (A) 293T and (B) SW480 cell lysates using anti-ST13/HIP RabMAb (Cat. AMM07993G), dilution 1:100,000.
B.Immunohistochemical analysis of paraffin-embedded human colonic adenocarcinoma tissue using anti-ST13/HIP RabMAb (Cat. AMM07993G). 
C. Immunohistochemical analysis of paraffin-embedded human normal colon tissue using anti-ST13/HIP RabMAb (Cat. AMM07993G). |
||
Specification |
|||
Quantity |
|
||
| Select | Brand | Catalog No. | Product Name | Pack Size | Type | Field of Research | Specification | Quantity | Price(USD) | |
| 1 | Leading Biology | APG02467G | CCK4 / PTK7 Antibody (clone 4F9) | 50 μl | Monoclonal Antibodies |
|
$495.00 | Add Ask | ||
| 2 | Leading Biology | AMM04683G | GALT Antibody (clone 4C11) | 50 μg | Monoclonal Antibodies |
|
$545.00 | Add Ask | ||
| 3 | Leading Biology | AMM01402G | Vimentin (Mesenchymal Cell Marker) Antibody - With BSA and Azide | 50 ug | Monoclonal Antibodies |
|
$395.00 | Add Ask | ||
| 4 | Leading Biology | APR08280G | LTA4H / LTA4 Antibody (clone 9G8) | 50 μl | Monoclonal Antibodies |
|
$495.00 | Add Ask | ||
| 5 | Leading Biology | AMM00172G | CD1a / HTA1 (Mature Langerhans Cells Marker) Antibody - With BSA and Azide | 50 ug | Monoclonal Antibodies |
|
$395.00 | Add Ask | ||
| 6 | Leading Biology | AMM05750G | CEBPA Antibody | 100 μl | Monoclonal Antibodies |
|
$545.00 | Add Ask |
 Leading Biology Inc.
2600 Hilltop DR, Building G, B Suite C138
Richmond, CA, 94806
Tel: 1-661-524(LBI)-0262
Email: info@leadingbiology.com
Leading Biology Inc.
2600 Hilltop DR, Building G, B Suite C138
Richmond, CA, 94806
Tel: 1-661-524(LBI)-0262
Email: info@leadingbiology.com
Complete this form and click send to ask us a question, request a quote or simply say hello.

You have 0 item in your cart

You have 0 item in your inquiry list
